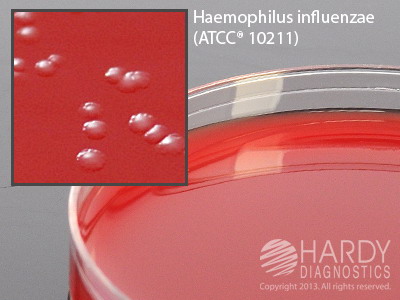
RTF Modified Casman Agar

Details
- Manufacturer: Hardy
- Mfr. Cat. # A68
- Brand Name: Hardy
Microbiology » Culture Media Plates
RTF Modified Casman Agar
Medix Item Code: HRA-0A68
$46.00 per Pack
List Price: $78.76
You Save: $32.76 (42%)
Size: 10 per pack
Special shipping requirements
- Refrigerated - This item is refrigerated and must ship by air with ice.
Features
- For the cultivation and differentiation of fastidious microorganisms
- Minimum Order: 10 Packs - Item is made to order
Description
RTF Casman Agar, for Haemophilus spp, sub for rabbitt blood, 15x100mm plate, by Hardy Diagnostics. (RTF Modified Casman Medium) For the cultivation and differentiation of fastidious microorganisms, especially Haemophilus spp. by hemolytic reactions. Refrigerate on arrival.